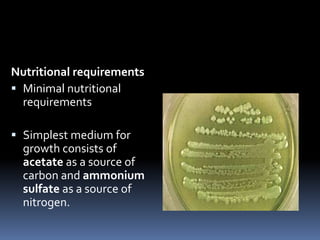
Nutritional requirements
 Minimal nutritional
  requirements

 Simplest medium for
  growth consists of
  acetate as a source of
  carbon and ammonium
  sulfate as a source of
  nitrogen.

This document discusses opportunistic pathogens and infections. It begins by defining an opportunistic pathogen as a microorganism that normally does not cause disease but can do so when the host's immune system is compromised. Examples of opportunistic bacteria that can cause infections in HIV/AIDS patients are provided, including Campylobacter, Flavobacterium, Pseudomonas, and Salmonella. The document also discusses two specific opportunistic pathogens in more detail: Pseudomonas aeruginosa and Escherichia coli (E. coli). It provides information on their characteristics, infections they can cause, and prevention strategies.